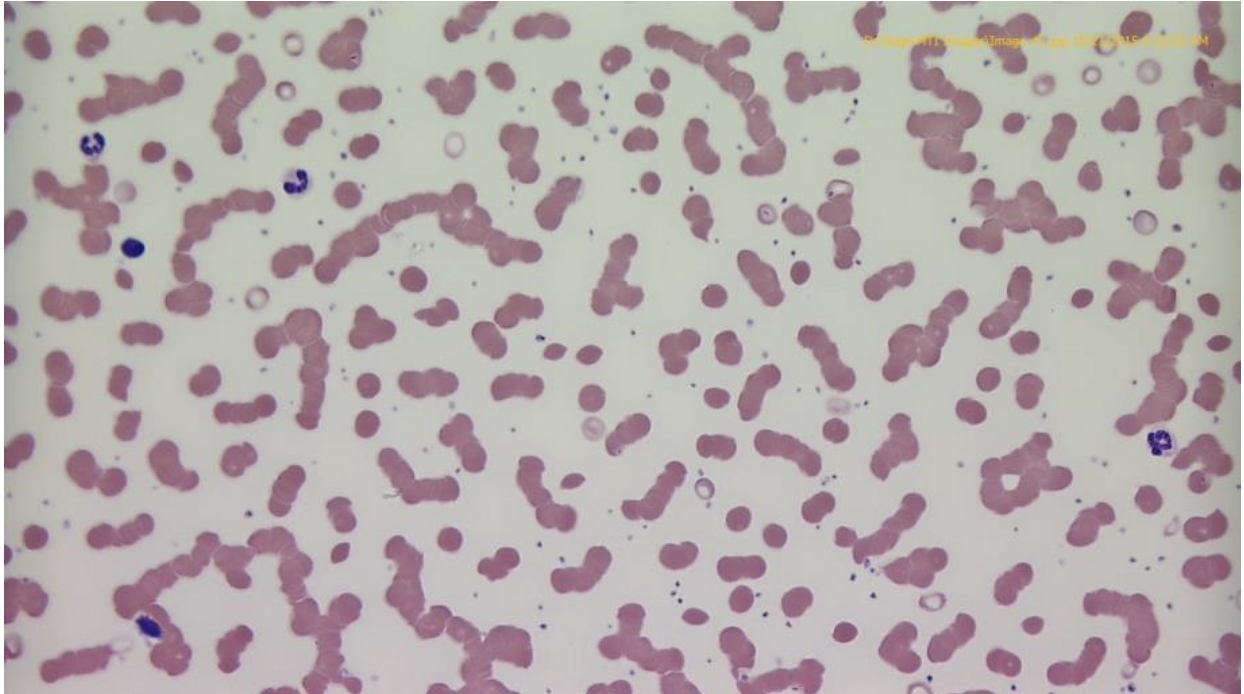
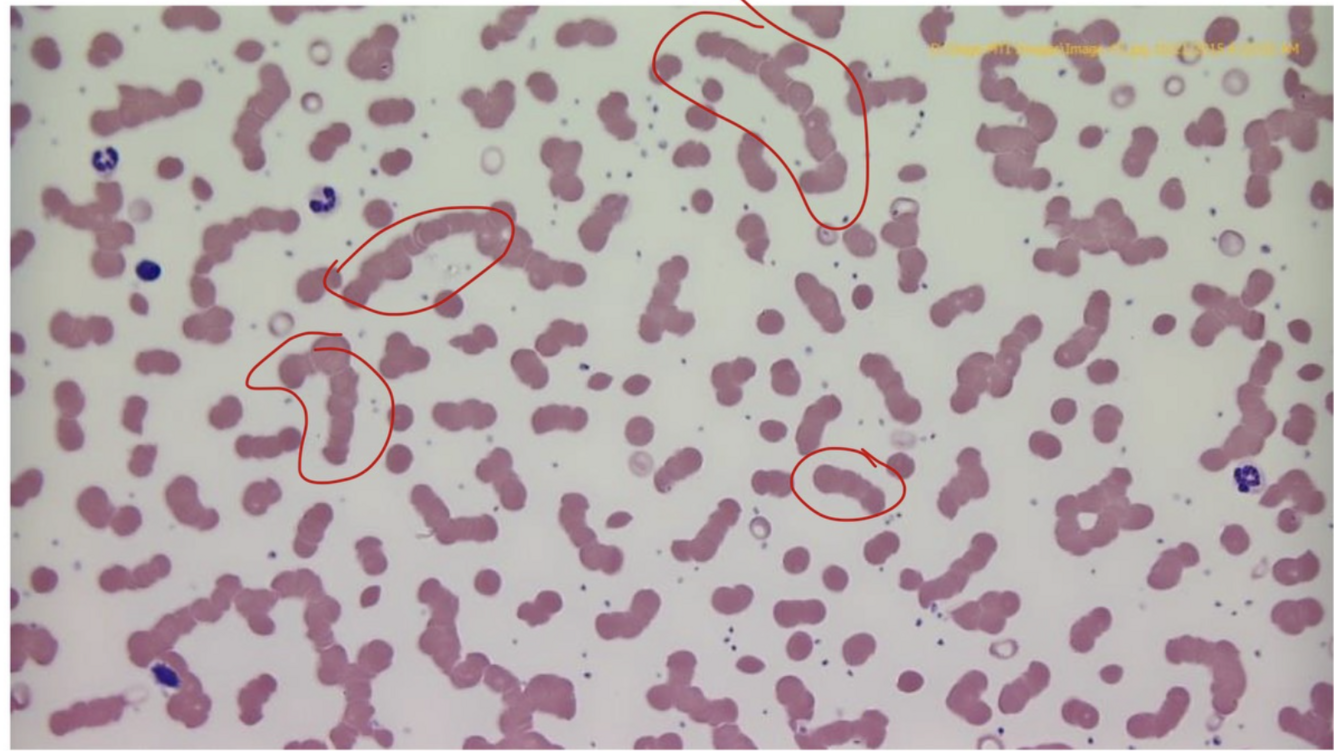
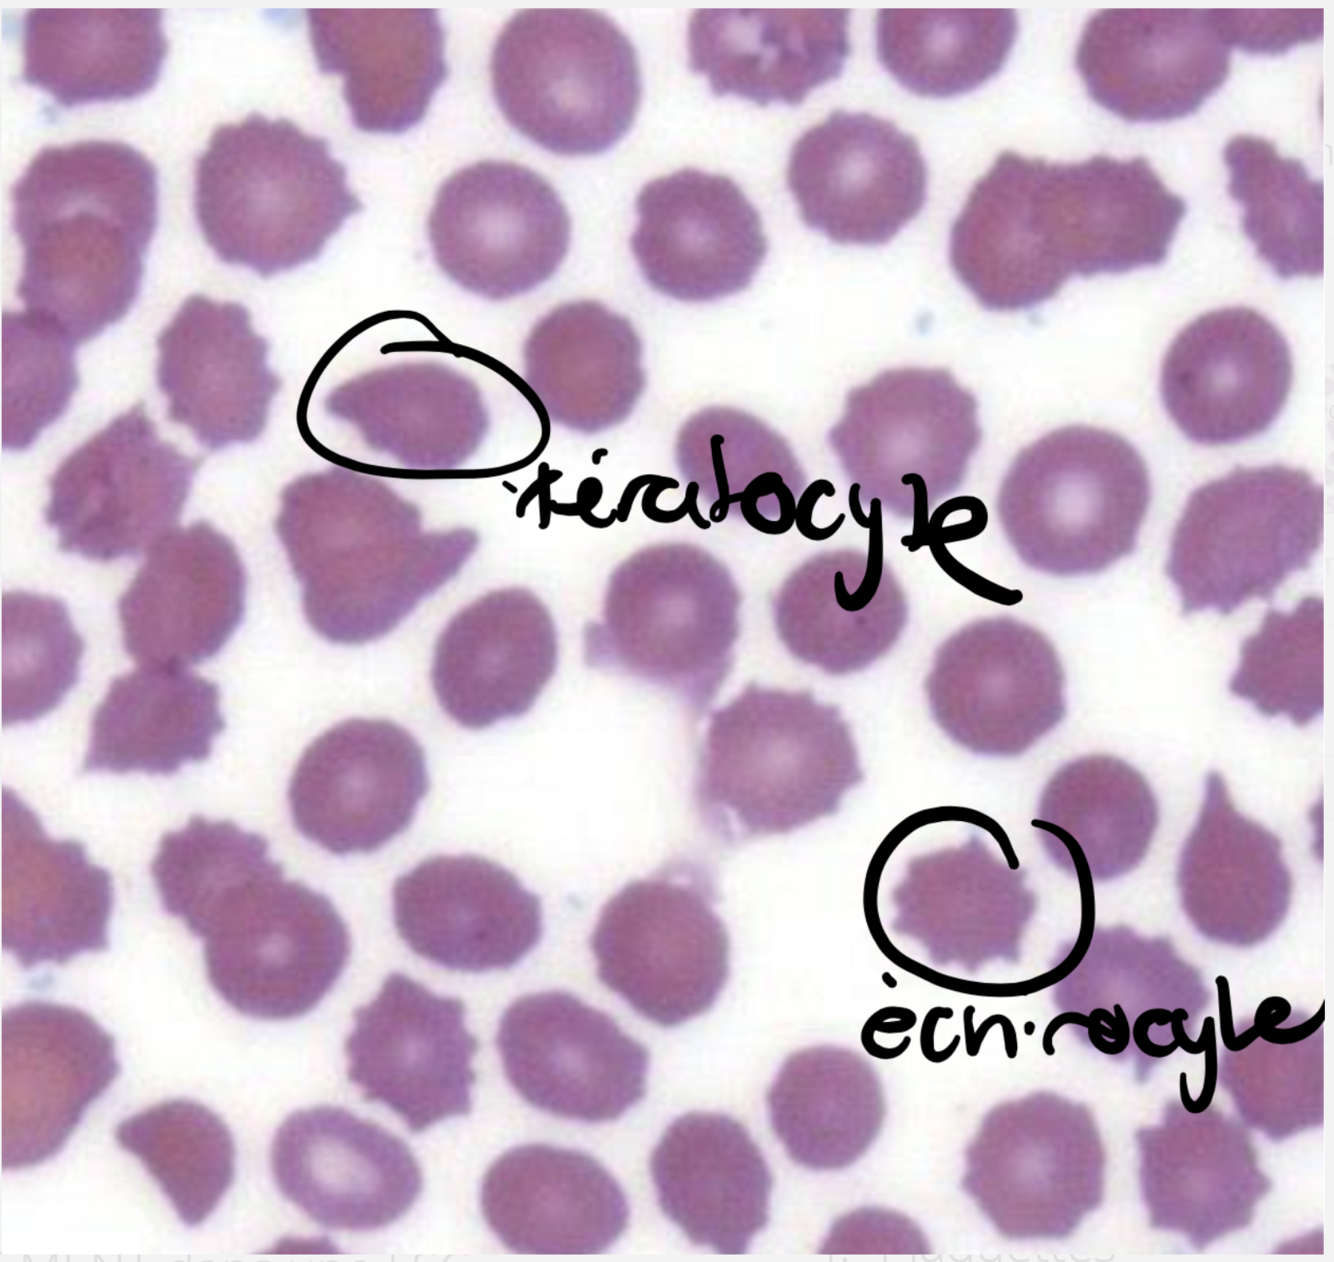
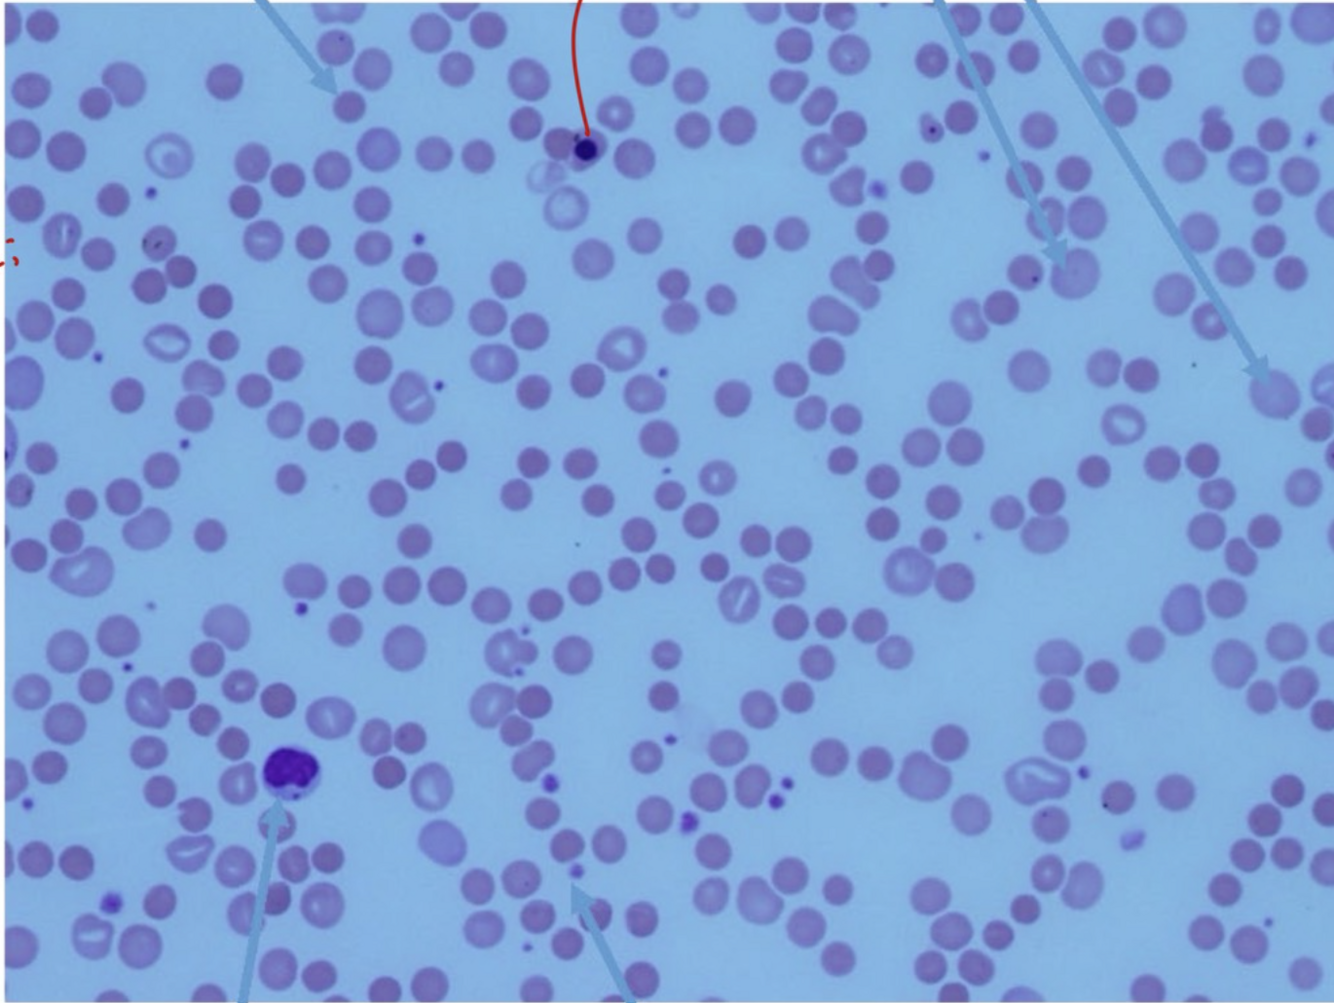
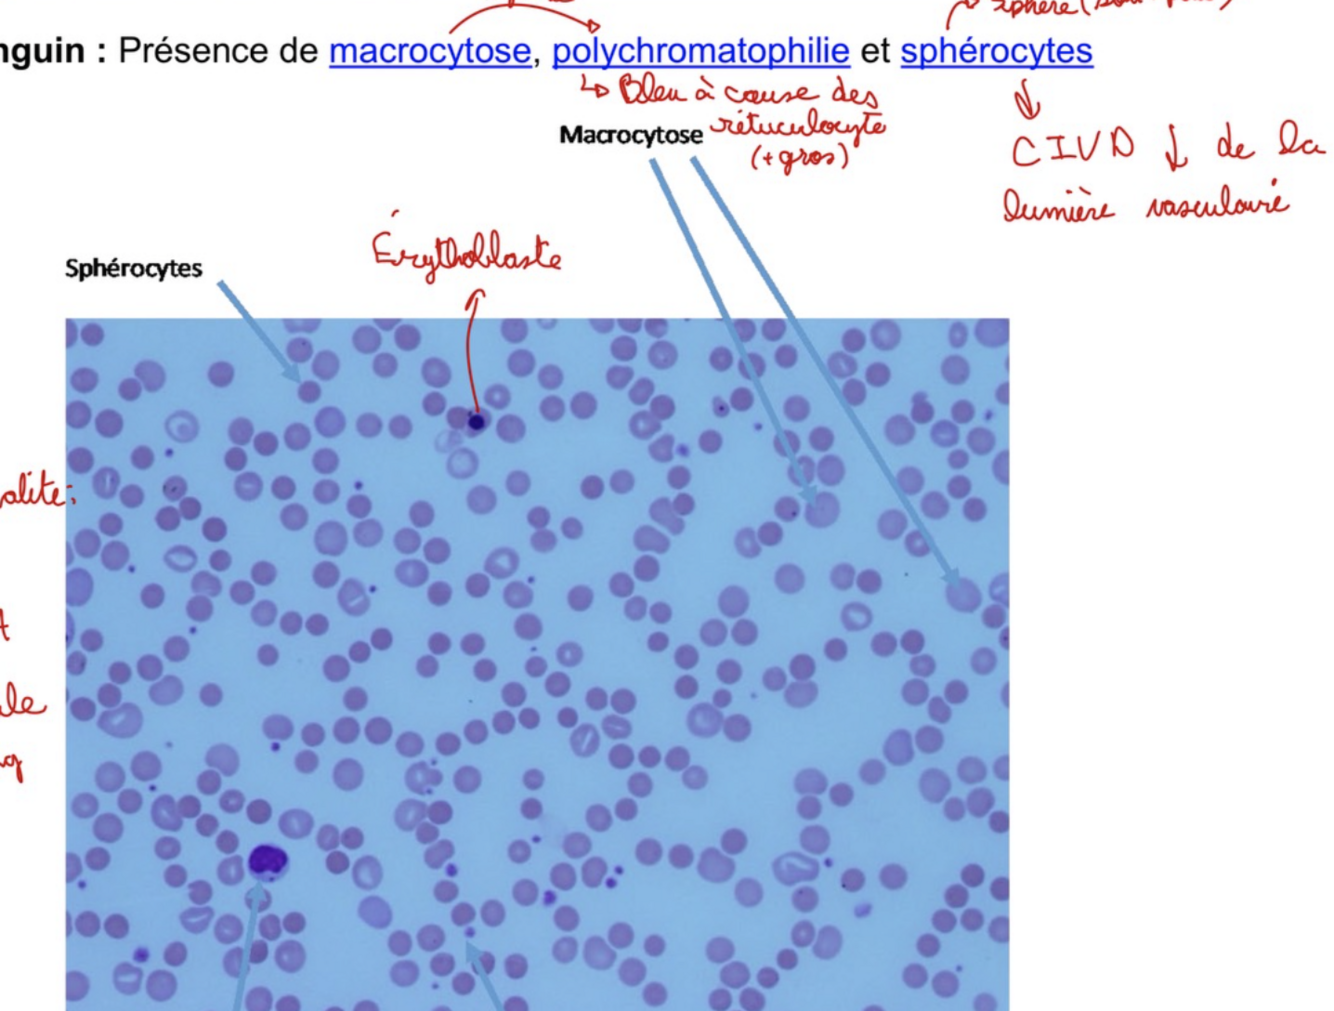

Cas 3
- Femme de 65 ans qui présente une maladie inflammatoire significative (arthrite rhumatoide )
- Prise AINS
- Pas de spoliation macroscopique ? Veut dire quoi?
- Examen physique: signes maladie inflammatoire, pas de signe d’insuffisance cardiaque
QUE PEUT-ON CONCLURE ?

CONCLUSION:
- Anémie microcytaire (VGM BAS), hypochrome (TGMH basse)
- Thrombocytose (inflammatoire)
- NEUTROPHILE SONT NORMAUX (On doit pas se fier à la valeur relative) (Pour la calculer tu dois prendre la relative et la mutiplié à la valeur de GB, donc, 0.40 x 9.5x10^9 = 3,8x10^9 ce qui est N.)
SPOLITAION MACROSCOPIQUE = saignement à vu d’oeil
CAS # 3 qu’est ce qu’on voit
- GR en ROULEAUX : SIGNE D’INFLAMMATION
- THROMBOCYTOSE
RÉSUMÉ de bilan martial selon fer, tranferrine, % Sat, Ferritine, Hepcidine

Lors d’inflammation:
- Bactéries ont besoin de fer, donc le cache et le fer sérique diminue
- Férritine, protéine de phase aigue (souvent augmenté)
- Hepcidine augmente pour limiter l’Absorption de fer

Cas # 3 (inflamation), diagnostic, différentiel et à quoi est dû la thrombocytose ?
Physiopathologie ?
Rappel: Anémie microcytaire hypochrome
Diagnostic:
- Anémie inflammatoire (des maladies chroniques)
Différentiel:
- Ferriprive (car la ferritine est normal au augmenté)
- Thalassémie
Thrombocytose
- Inflammatoire
Physiopathologie
- Diminution fabrication physiologique EPO
- Diminution réponse EPO
- Blocage utilisation fer intramédullaire via Hepcidine

Cas 4
Patiente 53 ans
Maladie chronique (diabète insulino-traité de longue date)
atteinte vasculaire
- rétinopathie diabétique,
- insuffisance artérielle des membres inférieurs/ claudication
intermittente, - Néphropathie pré-dialyse - en deterioration?
Surcharge cardiaque
- orthopnée, jugulaires distendues, surcharge pulmonaire, hépatomégalie, oedème des membres inférieurs
QUE peut-on conclure ? ET quel est notre réflexe lorsqu’on voit se type d’anémie?

Bilan:
- Anémie (Hb abaissé)
- Normochrome (VGMH N)
- Normocytaire (VGM N)
- Légère neutrophilie (8.4 x 10^9)/L (Valeur normale: 2.0-7.5)
QUAND C’EST ANÉMIE NORMOCHROME NORMOCYTAIRE, ON DOIT SE QUESTIONNER SI Y’A UN PROBLÈME DE MOELLE OU DE DESTRUCTION PÉRIPHÉRIQUE:
- Réticulocytes abaissés : RÉTICULOPÉNIE (PROBLÈME DE MO)
- La néphropathie doit nous sonner à l’oreilles puisque cela peut mener à une insuffissance rénale et qu’est ce qui est produit par les reins ?
Frottis du Cas 4 que peut-on voir ?et que veut-dire une vitesse de sédimentation augmentée ?

- Poikilocytose
(plusieurs formes GR) - Echinocytes (petit soleil avec des ptis piques) et kératocytes
(suggère mx métaboliques du foie/rein) - Vitesse de sédimentation augumentée (comme CRP ça suggère un état inflammatoire)
Keratocyte: ¢ avec un bout pointu
Quel est le terme qui définie des valeurs de réticulocytes abaissées
Réticulopénie
Comment appele-t-on une anémie avec réticulopénie
Anémie non-regénérative (car peu de réticulocyte qui sont les précurseurs des GR signifie qu’il y a un problème de synthèse rénérative)
Dans le Cas 4 la dame souffre d’une anémie normocytaire normochrome non-regénérative
Comment peut-on confirmer qu’une anémies est non-regénératives avec certitude?
Atteintes à la production des érythrocytes. Réticulocyte abaissés.
Les réticulocytes sont des formes immatures d’érythrocytes. Quand on est en anémie, le corps devrait typiquement auguementer la productions d’érythrocytes, auguementant alors le nombres de réticulocytes. Une réticulopénie pointe vers un problème de synthèse central (dans la moelle) et NON de déstruction des GR en périphérie (dans le sang)
Selon la FSC du Cas 4, quel serait le diagnostic différentiel
Rappel:
1. Anémie normocytaire normochrome
2. Réticulopénie (non-regénérative)
3. Légère neutrophilie
La réticulopénie pointe vers un problème de production central (dans la moelle) et NON de destruction des GR en périphérie (dans le sang)
Options possibles:
- Atteinte moelle osseuse
MAIS leucocytes et plaquettes sont N
si il y avait atteinte de moelle elle-même, il y aurait pancytopénie - Manque de facteur de croissance pour erythropoïèse
- Déficit en EPO
- Patiente avec INS. RENAL AVANCÉE - Absence de réponse à l’EPO
- Anémie des maladies chroniques

Quels serait les investigations complémentaires à faire pour le Cas 4
Rappel:
1. Anémie normocytaire normochrome
2. Réticulopénie (non-regénérative)
3. Légère neutrophilie
- Créatinine
pour insuffisance rénal - Dosage EPO
- Rx pulmonaire
jsp pourquoi c’est silly goofy - Bilan inflammatoire (martial)
pour rule out une anémie par inflammation chronique ig
EPO est produite par quel organe? TPO
EPO : Rein
TPO : Foie
Appareil juxtaglomérulaire
Décrire la production d’EPO ? Quand est-elle modulée ?
- Production stable !
- Modulée lorsque hémoglobine inférieure à 100, pour augementer le nb de GR
Qu’est-ce qui influence la production d’EPO
- Insuffisance rénale
- Paramètres inflammatoires
Réponse thérapeutique
Préalable: pas d’autres cause d’anémie dont ferriprive
Autres mécanismes physiopathologiques pr le cas 4,soit une anémie normocytaire normochrome
La prof est passé vrm quick la dessus
genre ongod 30s
Autres mécanismes physiopathologiques
- Hémodilution (bcp d’oedèmes, sutour chez les femmes enceintes)
- Déficits nutritionnels secondaire à la malabsorption entrainée par oedème muqueuse intestinale
- Rôle des medicaments (si prenait un anticoagulant avec possibilité de saignement digestif secondaire; certains medicaments antihypertenseurs pourraient inhiber l’EPO)

Cas 5
Homme 62 ans, antécédent d’HTA
Pénicilline haute dose pour une syphilis probablement
Évaluation clinique 3 semaines post:
- Suspecte anémie (fatigue, dyspnée, palpitations)
- Angine: à investiguer
- Examen physique: Ictère
Que peut-on conclure

FSC:
Hémoglobine : 68g/L anémie
VGM: 95fl legèrement macrocytaire
Reticulocytes: 180x10^9 réticulocytose
Anémie regénérative
la réticulocytose montre un effort de regénérer es érythrocytes donc production médullaire est adéquate
Expliquez les observations au frottis du Cas 5,Homme 62 ans, avec anémie macrocytaire régénérative
- Polychromatophilie
c’est simplement parce que le cytoplasme des réticulocytes est teinté bleu. Puisqu’on est en réticulocytose, le frottis est plus bleuté - Sphérocytes (le GR est en forme de sphère plutôt que biconcave)
Ceci arrive quand la membrane de l’érythrocyte a des parties “enlevée”.
Il existe deux causes générales:
- Intrinsèque (génétique): la membrance est mal attachée au cytosquelette. (pas cela dans ce cas-ci car il aurait eu des symptômes depuis qu’il est petit si c’est héréditaire.)
- Extrinsèque (immune ou non): anticorps, allo-immun mère-bébé, médicaments (PÉNICILLINE), brûlures, troubles electrolytiques importants
Quel serait le type d’anémie le plus probable du Cas 5
Rappel:
Anémie regénérative d’allure normochrome/normocytaire
Présence de sphérocytes, d’ictère et de péniciline
Anémie Hémolytique
- Les GR sont en forme de sphère, signe qu’elles se font attaquer
- Le patient a un ictère, signe d’hémolyse, car GR détruit relâche de la bilirubine dans le sang (non-conjugées)
- La production médullaire semble adéquate. Nous pouvons alors penser à de la destructionn des GR dans le sang périphérique
- Le patient a été exposé à de la péniciline. Il y a peut-être eu une réaction croisé avec le Gr
Quel est le diagnostic différentiel des anémies hémolytiques? Serait associé à quel type de GR ?
aka. c’est quoi les autres causes d’anémie hémolytique
Autres causes: Souvent Associé à des schizocytes (GR en fragments) plutôt que sphérocytes
- Traumatisme intravasculaire (ex. valves métalliques, malformation artério-veineuses)
- Microangiopathies
Schéma résumé des cause de l’anémie NORMOCYTAIRE

Quel serait le bilan complémentaire à faire pour le Cas 5
Rappel:
Anémie regénérative d’allure normochrome/normocytaire
Présence de sphérocytes
Quand c’est anémie normocytaire régnératif, c’est soit une perte de sang (pas le cas-ci) ou une hémolyse donc on fait un
Bilan d’hémolyse
- Bilirubine (Augmentée)
- LDH (marqueur de turnover cellulaire) (Augmentée)
- Haptoglobine (devrait diminué en hémolyse intravasculaire. Est utilisé pour attraper l’hémogline libre, donc elle diminue car elle est utilisé)
- Test à l’antiglobuline Coombs (identifie les Ac à la surface du GR. Résultat positif indique hémolyse auto-immune à cause d’un médicament la péniciline)
Si lien avec médicament ARRÊT
Pour le cas 5, considérer une transfusion car patient agé avec symptômes d’angine. On veut éviter un arrêt cardiaque. On veut rétablir son niveau O2.
Cas 6
- Homme 47 ans, à l’urgence
- Histoire:
Atteinte de l’état général
Dyspnée d’effort - Examen physique:
Pâleur, tachycardie
Stomatite (langue lisse)
Neuropathie périphérique (il a l’impression de marcher sur du coton ouaté)
Que peut-on conclure selon la FSC ?

FSC:
- Anémie (Hb : 72)
- Macrocytaire ++++ (VGM : 124)
- Neutophiles: Normaux
DÉJÀ NEUROPATHIE PRÉRIPHÉRIQUE = DÉFICIT EN B12
Frottis Cas 6 que voit-on ? Qu’est ce que ça veut dire ?

Neutrophiles hypersegmentés :
- 5 lobes nucléaires ou plus (Neutrophile normal est la photo ci-dessous à titre de comparatif)
- Soit un déficit en B12, folate ou à cause de médicament anti-métabolite
- anémie macrocytaire mégaloblastique

*c’est un signe classique d’un problème avec la maturation (particulièrement division) d’ADN *






